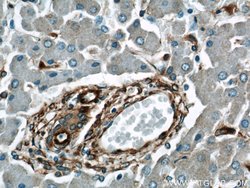
Vimentin Rabbit anti-Human, Mouse, Rat, Polyclonal, Proteintech:Antikörper:Primärantikörper

missing translation for 'onlineSavingsMsg'
Learn More
Learn More
Vimentin Rabbit anti-Human, Mouse, Rat, Polyclonal, Proteintech
Rabbit Polyclonal Antibody
145.00 € - 410.00 €
Spezifikation
| Antigen | Vimentin |
|---|---|
| Konzentration | 0.27 mg/mL |
| Anwendungen | Western Blot, Immunofluorescence, Flow Cytometry, Immunohistochemistry (Paraffin), Immunocytochemistry |
| Klassifikation | Polyclonal |
| Konjugat | Unconjugated |
| Produktcode | Marke | Menge | Preis | Menge & Verfügbarkeit | |||||
|---|---|---|---|---|---|---|---|---|---|
| Produktcode | Marke | Menge | Preis | Menge & Verfügbarkeit | |||||
|
16806713
|
Proteintech
10366-1-AP-20UL |
20 μL |
145.00 €
20 Mikroliter |
Log in om dit product te kopen Registreer vandaag om een webaccount aan te maken | |||||
|
16896703
|
Proteintech
10366-1-AP-150UL |
150 μL |
410.00 €
150 Mikroliter |
Log in om dit product te kopen Registreer vandaag om een webaccount aan te maken | |||||
Beschreibung
Vimentin is a member of the intermediate filament family. Intermediate filamentents, along with microtubules and actin microfilaments, make up the cytoskeleton. The protein is responsible for maintaining cell shape, integrity of the cytoplasm, and stabilizing cytoskeletal interactions. It is also involved in the immune response, and controls the transport of low-density lipoprotein (LDL)-derived cholesterol from a lysosome to the site of esterification. It functions as an organizer of a number of critical proteins involved in attachment, migration, and cell signaling. Mutations in this gene causes a domit, pulverulent cataract.Spezifikation
| Vimentin | |
| Western Blot, Immunofluorescence, Flow Cytometry, Immunohistochemistry (Paraffin), Immunocytochemistry | |
| Unconjugated | |
| Rabbit | |
| Mouse, Human, Rat | |
| P08670, P20152, P31000 | |
| 22352, 7431, 81818 | |
| Vimentin Fusion Protein Ag0489 | |
| Primary | |
| -20°C | |
| VIM |
| 0.27 mg/mL | |
| Polyclonal | |
| Liquid | |
| RUO | |
| PBS with 50% glycerol and 0.02% sodium azide; pH 7.3 | |
| VIM, vimentin | |
| VIM | |
| IgG | |
| Antigen Affinity Chromatography | |
| Antibody |
Haben Sie Verbesserungsvorschläge?Übermitteln Sie eine inhaltliche Korrektur
Berichtigung von Produktinhalten
Bitte geben Sie uns Ihr Feedback zu den Produktinhalten, indem Sie das folgende Formular ausfüllen.
Name des Produkts